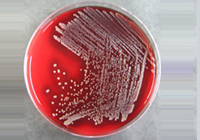

美国ATCC13047阴沟肠杆菌/青岛绿谷公司
产品报价:1500元
更新时间:2026/1/21 8:05:36
产地:美国
品牌:ATCC
型号:ATCC13047
厂商性质: 生产型,贸易型,服务型,
公司名称: 青岛绿谷商贸有限公司
海霞 : (18853230891) (0532-55671987)
(联系我时,请说明是在来宝网上看到的,谢谢!)

产品报价:1500元
更新时间:2026/1/21 8:05:36
产地:美国
品牌:ATCC
型号:ATCC13047
厂商性质: 生产型,贸易型,服务型,
公司名称: 青岛绿谷商贸有限公司
海霞 : (18853230891) (0532-55671987)
(联系我时,请说明是在来宝网上看到的,谢谢!)美国ATCC13047阴沟肠杆菌/青岛绿谷公司绿谷始终专注于为的第三方实验室提供高品质的试剂、检测仪器和加拿大Labplas无菌采样袋产品,加拿大BACTOBANK POLSE菌种保藏管,公司产品含试剂、ATCC标准菌株、通用试剂、生物试剂和仪器设备以及公司自主品牌ZOLG无菌采样袋、无菌均质袋5ul接种环、L型涂布棒等耗材,客户的满意是我们始终如一的追求!
绿谷专业提供微生物菌种订购服务,是ATCC菌种菌株的国内专业服务商,为客户提供质优价廉的标准菌种,是我们始终如一的追求。我公司提供的原装进口菌种都质量并附有证书,方便客户溯源和认可工作。美国标准菌种库(ATCC)和九大微生物菌种保藏中心的菌种资源、细胞系资源为代表的国内外微生物菌种资源,信息庞大,数据翔实,方便实用。常规检测标准菌种我们常年备有现货,全部原装进口,附带证书!
青岛中欧绿谷生物技术有限公司,员工40余人,是山东省青岛市一家生物公司。公司的产品主要用于实验室、学校实验、制药企业、化工、医疗等企事业单位和个体的实验室,充分发挥产品的有点,提高劳动效率。员工的技术,精良的设备,严格的管理是公司得以不断发展养大、产品能够赢得用户依靠的根本所在。“精确、”是我们生产精神和服务信念美国ATCC13047阴沟肠杆菌/青岛绿谷公司
几年来,青岛中欧绿谷生物科技有限公司在吸取国内外先进技术和工艺的基础上,集多年来在实验器材行业的智慧和经验,产品的精度、稳定性、可靠地位,我公司生产的ZOLG牌接种环,取样勺,L型涂抹棒,采样袋产品已逐步从一代产品升级为第六代产品,并仍在研发更为高品质的产品。凭着先进的技术、高品质服务,我公司产品跻身于国内生物产品ATCC产品,3M检测片产品以及ZOLG产品,已成为国产品牌,产品遍及各地,我们用心倡导:以市场为导向,以科研为龙头,以创新为手段,用心做国内外市场。
美国ATCC13047阴沟肠杆菌/青岛绿谷公司
QQ:2829704801
18853230891
0532-55671987